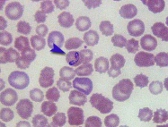
piroplasmose

Vacune a su perro lo antes posible
Le aconsejo que vacune a su perro bastante temprano porque, desde la edad de 2 meses, el cachorro ya no está protegido por anticuerpos maternos.
A pesar de que recibe una primera inyección del criador, se necesitan una o dos inyecciones más, y este es de un mes de diferencia.
Estas vacunas son esenciales para:
- Proteger al perro adulto, que con la edad, ve disminuir sus defensas inmunes
Para la protección de su acompañante, será necesario un recordatorio anual. (No olvide las fechas de retiro porque, en caso de olvido, si su animal entra en contacto con un perro enfermo, podrá contraer la enfermedad sucesivamente).
Estoy aquí para informarle y guiarlo, se le enviará un recordatorio.
Para todas las patologías que discutiremos a continuación, existe una vacuna. Ella puede proteger a tu amigo.
PRINCIPALES ENFERMEDADES INFECCIOSAS CANINAS

El moquillo
Enfermedad muy contagiosa especialmente para perros jóvenes o animales debilitados.
Puede causar la muerte del animal.
La enfermedad generalmente comienza con fiebre, luego secreción nasal y ojo.
Los pulmones (pneumonía) y los intestinos (gastroenteritis) se ven afectados y, finalmente, el sistema nervioso.

El parvovirus canino
Es una virosis (enfermedad causada por un virus) muy extendida en las comunidades caninas.
Causa gastroenteritis hemorrágica que puede ser fatal.

La hepatitis contagiosa
Un poco similar a la hepatitis viral humana, con más flujos oculares.
El animal puede seguir siendo portador y excretor del virus.

La rabia
La rabia es una zoonosis (infección transmisible) que puede transmitirse a los humanos.
Se transmite por la saliva.
En Europa, la rabia se encuentra principalmente en animales salvajes (zorros, murciélagos). Mata a 50,000 personas anualmente en el mundo.
Desde 2001, Bélgica ha estado libre de furia.
→ Importante: si viaja al exterior con su perro o gato, ¡debe vacunarse!

La leptoespirosis
Enfermedad aguda a subaguda caracterizada por fiebre, trastornos gastrointestinales, nefritis y, en ocasiones, ictericia (ictericia) causada por hepatitis.
Enfermedad transmitida por la orina de una rata o perro contaminado.

La tos de las perreras
Se caracteriza por una tos fuerte y seca que puede extenderse a los bronquios y los pulmones. Ocurre a menudo después de una estancia en una perrera.

Virus del herpes canino
Muy común en el ganado, principalmente causa mortalidad en cachorros recién nacidos.
Piroplasmosis
Enfermedad transmitida por garrapatas, parásito que causa la destrucción de glóbulos rojos.

Leishmaniasis
La leishmaniasis es una enfermedad crónica causada por un parásito microscópico llamado Leishmania infantum.
Este parásito se transmite por la picadura de un insecto, el flebótomo, que se asemeja a un mosquito muy pequeño y está activo de mayo a septiembre en la cuenca del Mediterráneo.
Es una enfermedad de crecimiento lento que a veces puede ser muy grave en los perros.
